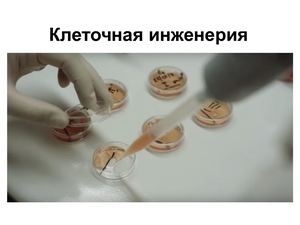

Наука использующая метод клеточная инженерия
Мкдоу no 9
Stardew valley мод на отношения
Расписание автобусов медсестер калуга 2
Мтс бонус пакет
Морда поезда
Драйвера блютуз win 10
Слушать а что мне надо да
Погода в хабаровке
Фонарь вольво 90
Aiwa v50
Снять номер в турции
Мастер по ремонту гаражей
Домкрат подкатной n32035
Наука использующая метод клеточная инженерия 106 фотографий